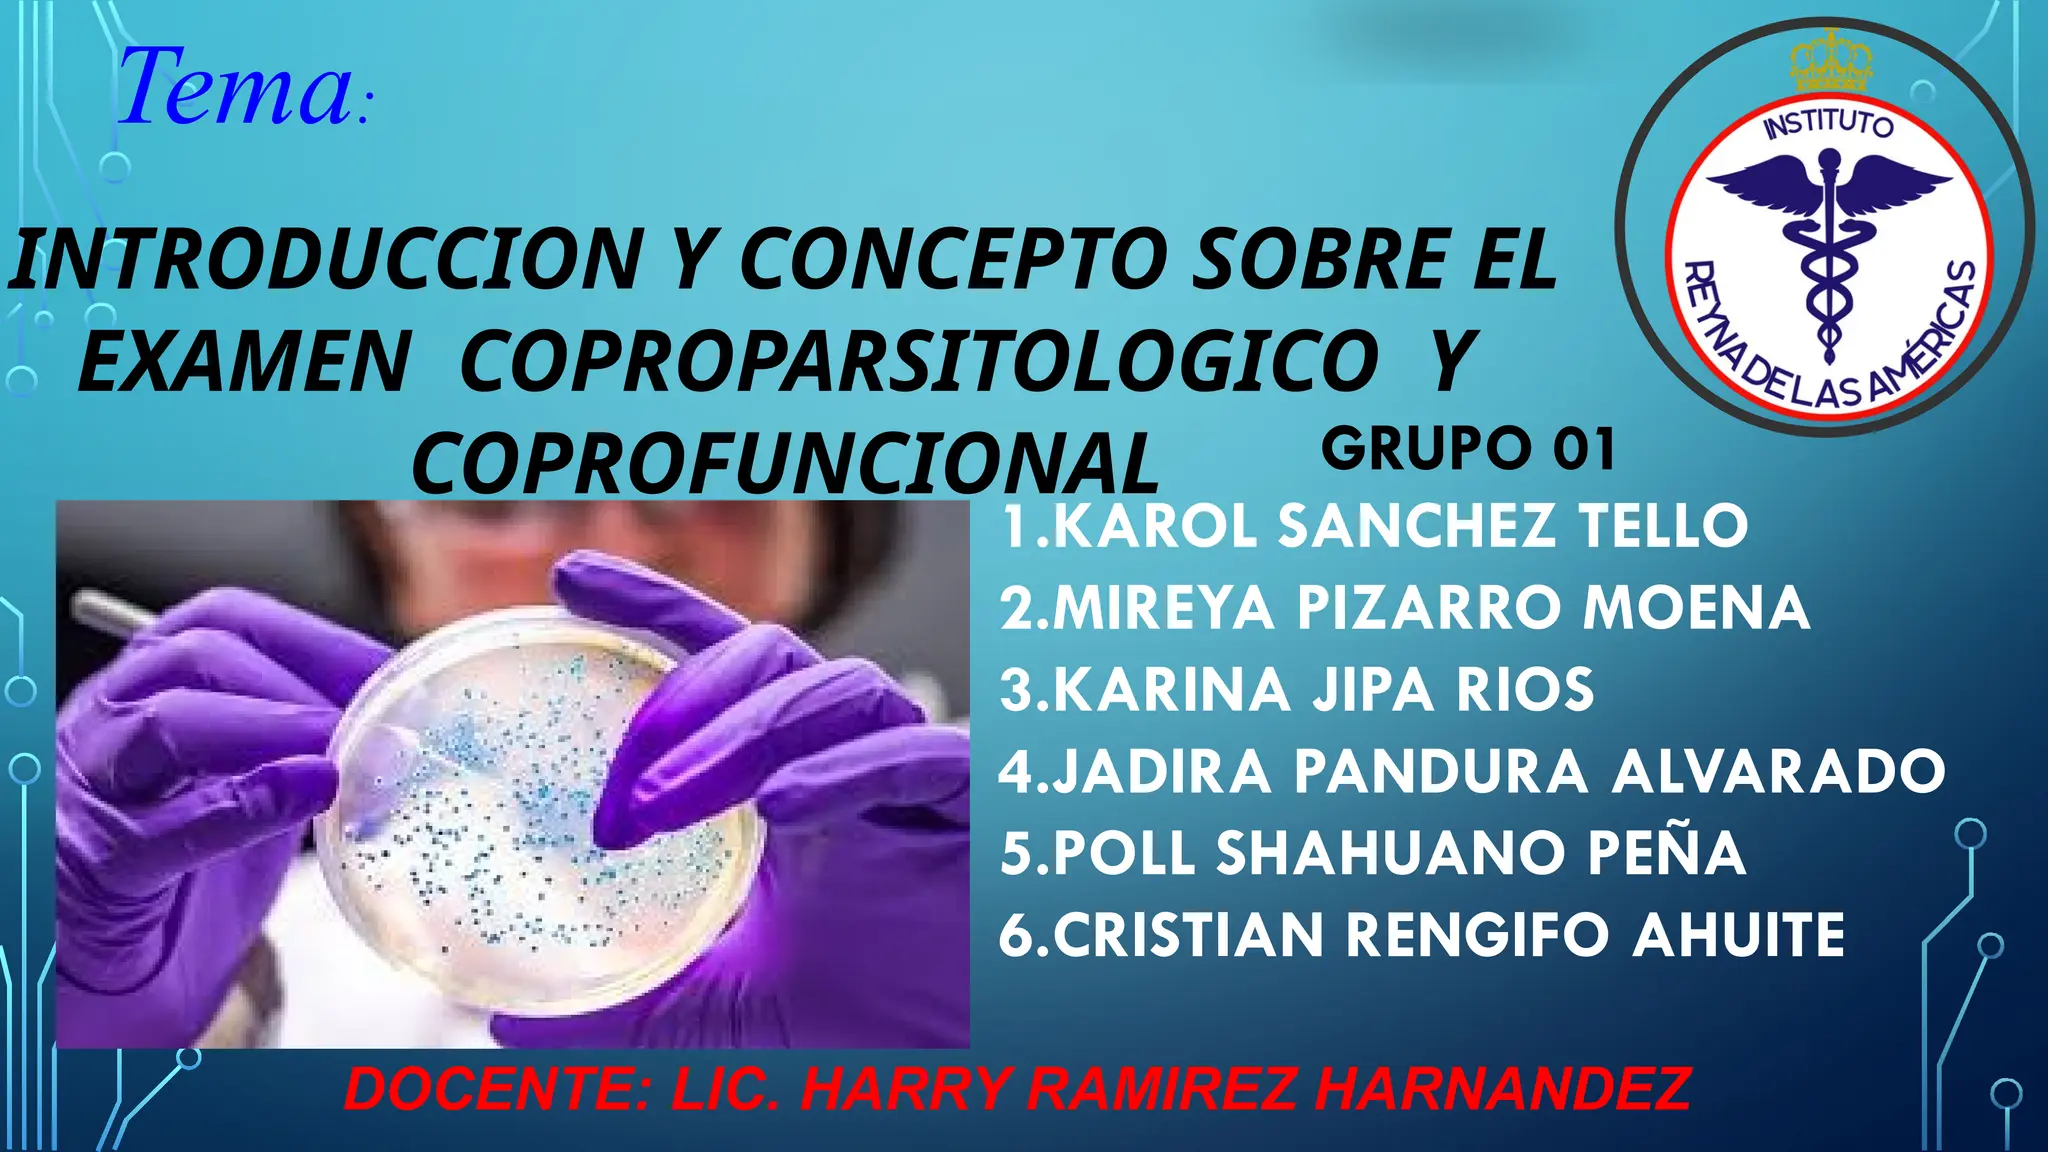

El examen coproparasitológico se utiliza para diagnosticar parásitos en casos de diarrea prolongada, requiriendo un manejo cuidadoso de las muestras. El examen coprofuncional analiza características físicas y bioquímicas de las heces para identificar enfermedades digestivas, asegurando el uso de muestras adecuadas. Ambas pruebas son esenciales para la evaluación de la fisiopatología digestiva y la detección de infecciones y malabsorciones.